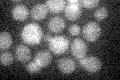
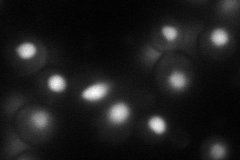
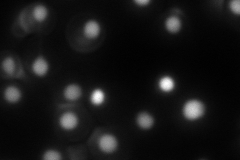
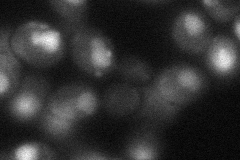

View description
Component of the DNA ligase IV complex that mediates nonhomologous end joining in DNA double-strand break repair; physically interacts with Dnl4p and Nej1p; homologous to mammalian XRCC4 protein
Localization:
Intensity:
Fold change:
Significance:
-
C’ GFP library in SD
below threshold16.86 -
N' NOP1pr-GFP in SD
nucleus79.6103 -
N' TEF2pr-mCherry in SD
nucleus78.9214 -
N' NATIVEpr-GFP in SD

below threshold20.61 -
N' TEF2pr-VC and Cyto-VN in SD
nucleus36.9796 -
C’ GFP library in SD+DTT

cytosol16.450.97No -
C’ GFP library in SD+H2O2

cytosol17.421.03No -
C’ GFP library in Starvation Media

cytosol13.470.79No -
C’ GFP library on the background of Pup2-DaMP

below threshold -
C’ GFP library on the background of CCT mutant

below threshold17.72111.05074No
